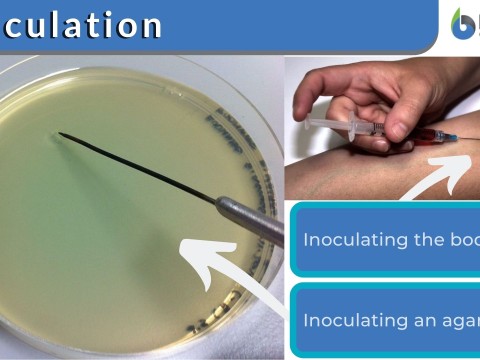
inoculation

inoculation
🇬🇧/ɪˌnɒkjuˈleɪʃn/ 🇺🇸/ɪˌnɑːkjuˈleɪʃn/📚 23826GREtaking a vaccine as a precaution against contracting a disease
noun [具体名词][医] 接种;接木;接插芽
At an orientation meeting, the travelers were told that a visa, a landing card, and evidence of inoculation against typhoid fever would be needed by each of them.
在一次介绍会上,这些旅行者被告知每人都需要签证、入境卡和伤寒疫苗接种证明。
单词造句:
- 网友用“Inoculation”造句精选
- Serum samples were collected on 30, 60 and 140th days post inoculation. 分别于接种后30、60和140天收集血清样本。